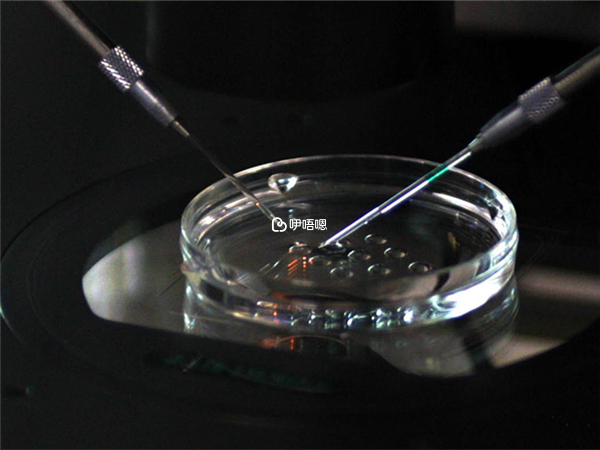

天津983醫院是一所三甲綜合醫院,簡稱天津983醫院,該醫院試管口碑在當地是比較好的。目前此醫院開展夫精人工授精技術、常規體外受精-胚胎移植技術、卵胞漿內單精子顯微注射技術,還不能開展第三代試管嬰兒技術,如果男女雙方染色體異常或者存在遺傳性疾病,導致無法自然受孕的,可以選擇天津其他的三代試管醫院。
第三代試管嬰兒是一種比較新的試管嬰兒技術,比二代不同的是多了植入前胚胎遺傳學診斷技術,目前,天津983醫院不能做第三代試管,不過全國開展三代試管的醫院也不少,有需要可以前往天津其他醫院以及其他地區,有三代試管需求的家庭可以前往以下幾個醫院進行試管。
| 第三代試嬰兒醫院管 | ||
| 醫院 | 地址 | 技術 |
| 天津市中心婦產科醫院 | 天津市南開區南開三馬路156號 | 一代、二代、三代試管 |
| 北京大學第三醫院 | 北京市海淀區花園北路49號 | 一代、二代、三代試管 |
| 解放軍總醫院第一醫學中心 | 北京市海淀區復興路28號 | 一代、二代、三代試管 |
| 河北醫科大學第二醫院 | 河北省石家莊市新華區和平西路215號 | 一代、二代、三代試管 |
基本資訊來自醫院官網或醫院內公示資訊或醫生本人提供,如有侵權,請按照平臺提供的渠道通知